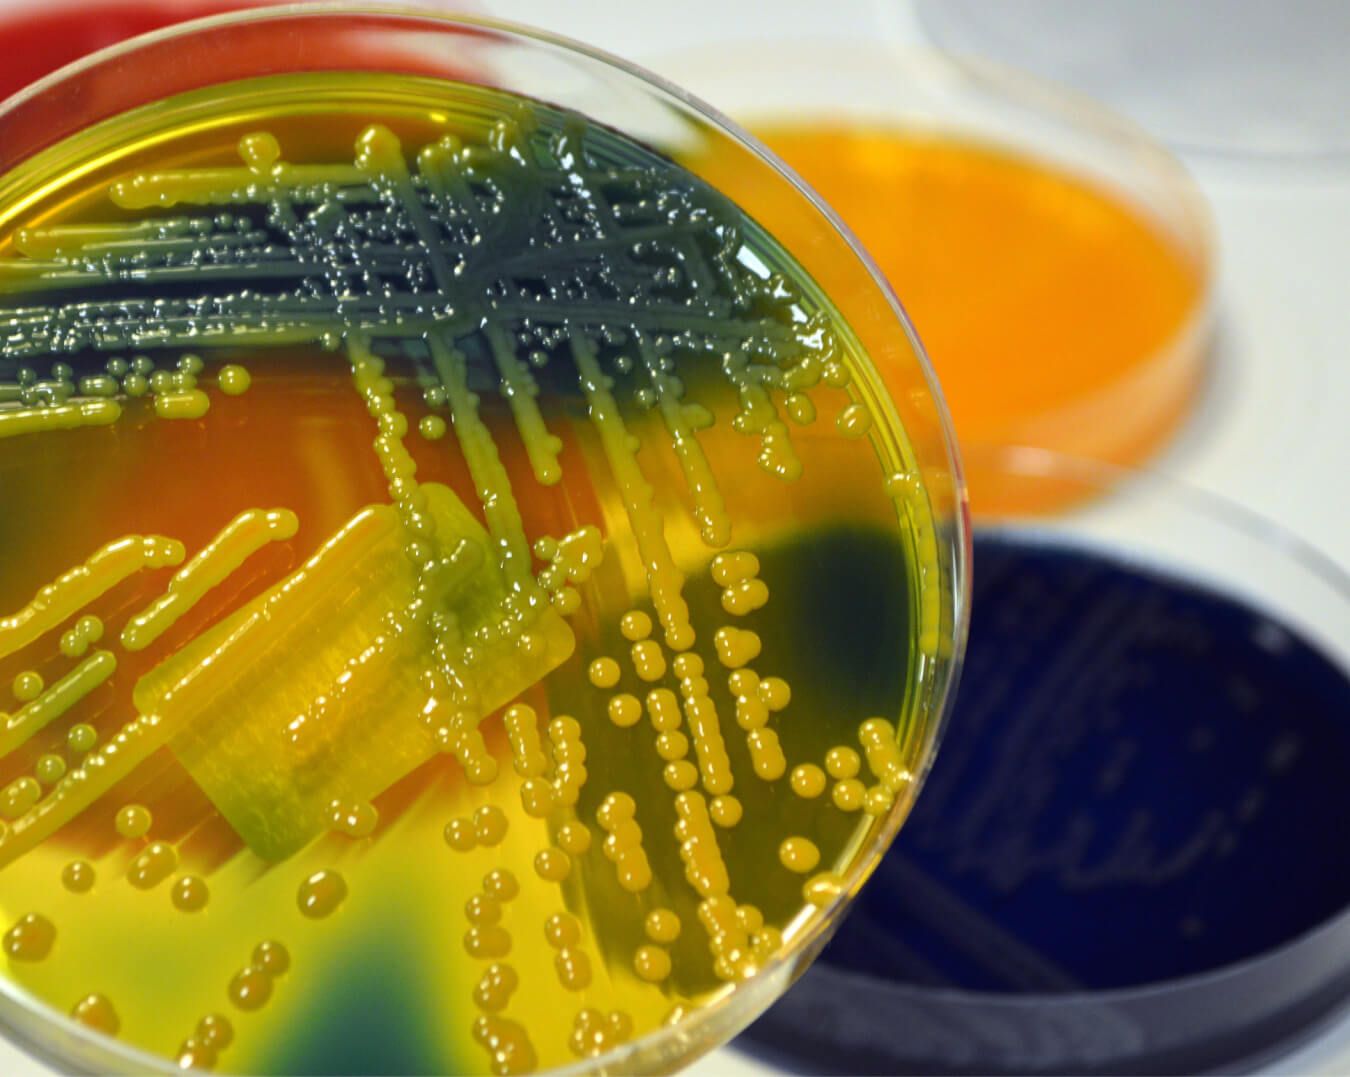
Post image

We're here to help. Call 310-444-1200 or fill out the form below and our team will reach out shortly.
Bloodstream infections are some of the deadliest infections patients can contract in a hospital setting. According to a new study, often hospitals fail to treat such infections appropriately with antibiotic treatment.
The results of the study were published recently in the Journal PLOs One and focused on the identification of bloodstream infections in hospitals and appropriate treatment. However, the study found there were differences in treatment in community hospitals and specialized care hospitals.
The study found it has become harder for hospitals to treat patients who develop bloodstream infections, because of the increase in the number and types of antibiotic-resistant superbug. As part of the study, researchers analyzed approximately 1,500 patients who contracted bloodstream infections in community hospitals between 2003 and 2006. They found approximately 30% of the patients were not given appropriate antibiotic therapy to treat those infections.
Patients who are being treated in a community care center, hospital or nursing home were much more likely to be given improper treatment. Patients whose bloodstream infections involve impaired function or bacteria that are resistant to multiple drugs were also most likely to be given inaccurate treatment.
Bloodstream infections are also called central line-associated bloodstream infections and these are some of the deadliest hospital-acquired infections. These infections are typically contracted due to the contamination of the central lines that are used to transmit drugs and nutrition to a patient in an intensive care unit. The central lines, tubes and catheters can become contaminated due to improper handling by staff members and as a result, the pathogens can be transmitted into a patient's bloodstream directly. Infection can set in rapidly, because the deadly pathogens have a direct route to the bloodstream of the patient through IV lines.